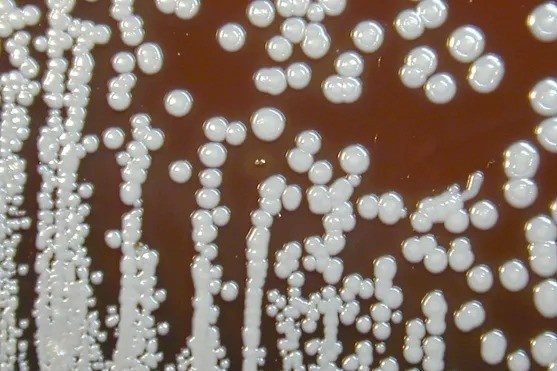

|
| Bệnh nhi chưa được tiêm viêm não Nhật Bản. Ảnh minh họa: Freepik. |
Theo thông tin từ Trung tâm Kiểm soát Bệnh tật (CDC) tỉnh Đắk Lắk ngày 24/6, bệnh nhi là bé N.X.N. (nam, 4 tuổi, huyện Krông Pắk, tỉnh Đắk Lắk).
Trước đó, bé N. bắt đầu sốt vào ngày 16/6. Ba ngày sau, trẻ nôn ói ra nước, được người nhà đưa đi khám tại Trung tâm Y tế huyện Krông Pắk. Ngày 20/6, tình trạng của bé N. tiến triển nặng, phải chuyển lên Bệnh viện Đa khoa vùng Tây Nguyên để điều trị.
Tại đây, bệnh nhi được chẩn đoán co giật chưa rõ nguyên nhân, theo dõi viêm não màng não, theo dõi nhiễm trùng huyết, đã xử trí dịch truyền và các thuốc hỗ trợ khác.
Ngày 23/6, kết quả xét nghiệm từ Viện Vệ sinh Dịch tễ Tây Nguyên xác định bệnh nhi dương tính với virus viêm não Nhật Bản. Đến nay, trẻ vẫn đang được tích cực chăm sóc, điều trị tại Bệnh viện Đa khoa vùng Tây Nguyên.
Trước đó, Đắk Lắk ghi nhận trường hợp mắc viêm não Nhật Bản đầu tiên ở bệnh nhi L.T.B.T. (nam, 11 tuổi, thị xã Buôn Hồ, tỉnh Đắk Lắk).
Do tình trạng nặng, bé T. được chuyển đến Bệnh viện Nhi đồng 2 (TP.HCM) để điều trị với chẩn đoán viêm não màng não, nhiễm trùng huyết, xuất huyết tiêu hóa. Trẻ có kết quả xét nghiệm dương tính với bệnh viêm não Nhật Bản vào ngày 19/6.
Đây là bệnh nhiễm trùng cấp tính do virus viêm não Nhật Bản gây tổn thương ở não và hệ thần kinh trung ương. Bệnh lây truyền từ súc vật (như heo, chim) mang virus sang người qua muỗi đốt có tên là Culex.
Ở Việt Nam, viêm não Nhật Bản thường xảy ra cao điểm trong mùa hè (từ tháng 5 đến tháng 8)
Biểu hiện chính của bệnh là sốt cao, đau đầu dữ dội, nôn mửa, co giật, hôn mê... Bệnh thường diễn biến nặng, để lại di chứng thần kinh như liệt, mất trí nhớ và tỷ lệ tử vong cao.
Đối với người mắc bệnh tim, việc di chuyển đường dài để khám bệnh luôn đặt ra nhiều thách thức rất lớn. Nhưng nhờ sự phát triển của Telehealth, bệnh nhân giờ đây có thể khám chữa bệnh từ xa. Mục Sức khỏe của Zing giới thiệu đến bạn đọc cuốn sách Câu chuyện từ trái tim - BS Nguyễn Lân Hiếu.
Câu chuyện từ trái tim của bác sĩ Nguyễn Lân Hiếu là tập hợp những ghi chép về các vấn đề thời sự xã hội, từ y tế, giáo dục đến môi trường, thể hiện trăn trở của tác giả trong các vấn đề xã hội.
Với văn phong nhẹ nhàng nhưng ngắn gọn do được ông viết trong khoảng thời gian giữa những ca mổ, cuốn sách như một giãi bày về nghề y, về trái tim người thầy thuốc và trái tim của bệnh nhân, đặc biệt là những bệnh nhân tim mạch.